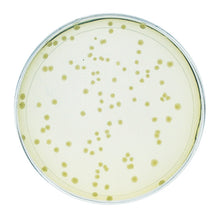
Load image into Gallery viewer, Edvotek 331 Investigating Synthetic Biology

Teach your students about synthetic biology with this exciting and exclusive experiment!
Students use PCR to amplify the coding sequence of the BSMT1 enzyme. This interesting enzyme is responsible for the formation of methyl salicylate, a chemical with a strong "wintergreen" odor. The PCR product is purified, restriction digested, and inserted into a plasmid vector. The resulting recombinant DNA is then used to transform E. coli BactoBeads.
Finally, students design an experiment to express the enzyme from their transformants and perform a smell test to confirm that the bacterial factories are working!
Kit includes: PCR EdvoBeads™, primer mix concentrate, template DNA concentrate, universal DNA buffer, ultrapure water, DNA standard marker, 10X gel loading solution, purification and wash buffers, spin columns and reservoirs, Dryzyme® mix, Dryzyme® reconstitution buffer, enzyme reaction buffer, vector cut with EcoRI and HindIII, T4 DNA ligase, ReadyPour LB agar, LB medium, BactoBeads™ (Host), Calcium Chloride, competent cell solution, control DNA, recovery broth, Kanamycin, IPTG, Salacylic acid, wintergreen scent, 50X electrophoresis buffer, agarose, SYBR Safe Stain, microcentrifuge and PCR tubes, 10 ml pipet, 50 ml conical tubes, sterile loops.
All you need: thermal cycler, horizontal gel electrophoresis apparatus, DC power supply, UV transilluminator, microcentrifuge, two water baths, shaking incubation oven, microwave or hot plate, pipet pump, micropipets, two flasks at least 125 ml, lab gloves, ice, bleach.
For 5 groups of students.
Time requirements:
Module I: 2 hours
Module II: 60 mins
Module III: 2 hours
Module IV: 75 mins
Module V: 2 hours + overnight
Module VI: 3 hours 20 mins + overnight
Module VII: 15 mins
*This experiment includes a multiple day transformation*